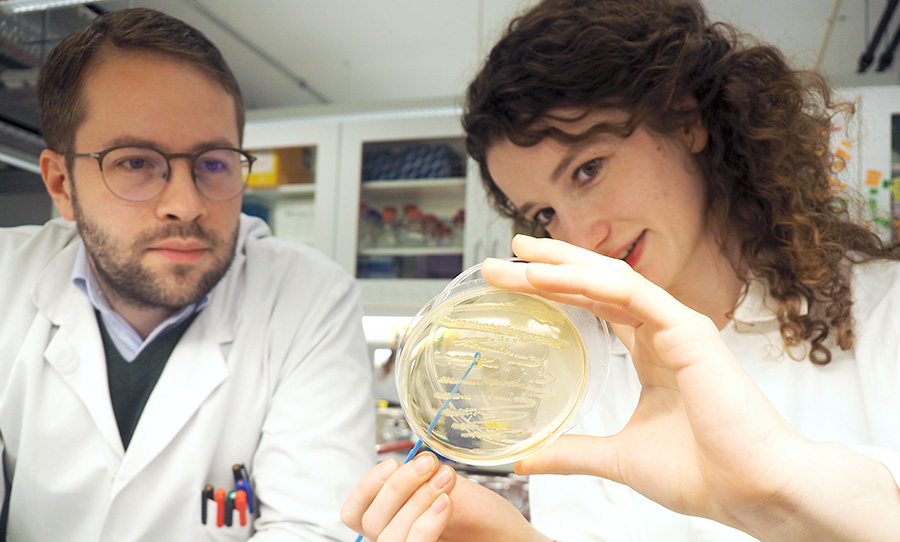

Microbial Biotechnology - Trygve Brautaset Lab
Microbial Biotechnology
– Trygve Brautaset
Members
Luciana Fernandes de Brito (Postdoc)
Sigrid Hakvåg (Postdoc)
Marta Katarzyna Irla (Postdoc)
Eivind Bøe Drejer (Phd Candidate)
Agnieszka Gawin (Phd Candidate)